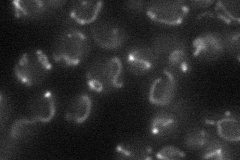
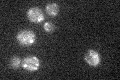

View description
Mitochondrial protein that interacts with the 5'-untranslated region of the COB mRNA and has a role in its stability and translation; found in a complex at the inner membrane along with Pet309p
Localization:
Intensity:
Fold change:
Significance:
-
C’ GFP library in SD

mitochondria24.04 -
N' NOP1pr-GFP in SD
mitochondria23.8857 -
N' TEF2pr-mCherry in SD

mitochondria9.34903 -
N' NATIVEpr-GFP in SD

below threshold17.6541 -
N' TEF2pr-VC and Cyto-VN in SD

#N/A0 -
C’ GFP library in SD+DTT

mitochondria24.261No -
C’ GFP library in SD+H2O2

mitochondria26.71.11No -
C’ GFP library in Starvation Media
mitochondria19.370.8No -
C’ GFP library on the background of Pup2-DaMP

mitochondria -
C’ GFP library on the background of CCT mutant

mitochondria23.42680.973955No
